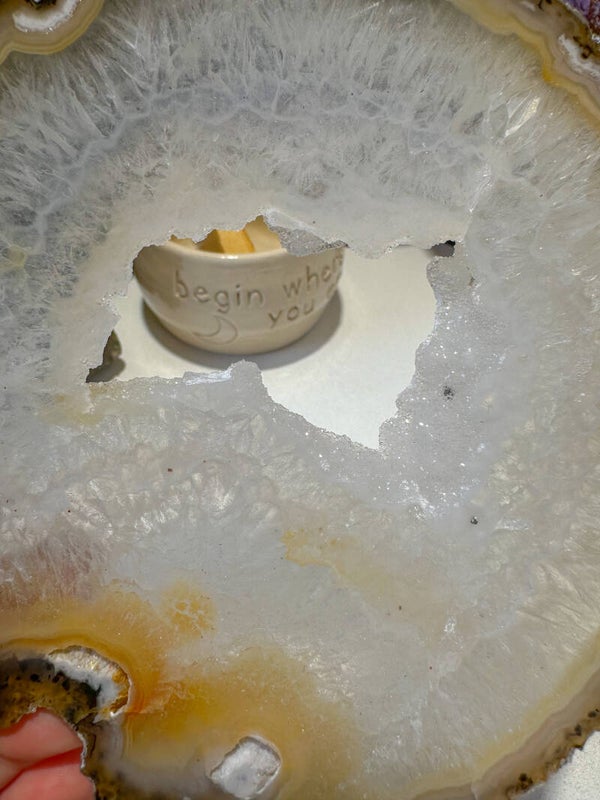

Agaatschijf
Uitverkocht
€ 24,40
Hele mooie grote A kwaliteit Agaatschijf met allemaal kristallen binnen in.
210gram.
Agaat werkt aardend, stabiliserend en beschermend. De steen werkt kalmerend, laat je veilig voelen en zorgt voor zowel geestelijke als emotionele rust en balans. Het helpt jezelf accepteren en helpt vertrouwen hebben in jezelf 🤎.